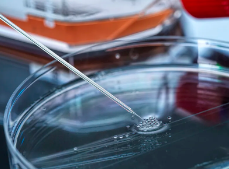
image.png

干細(xì)胞治療近視費(fèi)用多少,效果如何
2024-11-18 16:04:21 來源: 小編 咨詢醫(yī)生
本文將詳細(xì)介紹干細(xì)胞治療近視的原理、費(fèi)用及效果,幫助大家更好地了解這一前沿技術(shù)。
干細(xì)胞治療近視是一種新興的近視矯正方法,它通過運(yùn)用干細(xì)胞技術(shù),修復(fù)或替換受損的視網(wǎng)膜細(xì)胞,從而改善視力。以下是關(guān)于干細(xì)胞治療近視的費(fèi)用和效果方面的詳細(xì)介紹。
一、干細(xì)胞治療近視的費(fèi)用
干細(xì)胞治療近視的費(fèi)用因地區(qū)、醫(yī)院和治療方法的不同而有所差異。在我國,一般來說,干細(xì)胞治療近視的費(fèi)用大約在10萬元至30萬元人民幣之間。這個(gè)價(jià)格包含了干細(xì)胞培養(yǎng)、手術(shù)及術(shù)后恢復(fù)等費(fèi)用。需要注意的是,這是一個(gè)大致的區(qū)間,具體費(fèi)用還需根據(jù)實(shí)際情況咨詢相關(guān)醫(yī)院。
二、干細(xì)胞治療近視的效果
1.效果顯著
干細(xì)胞治療近視的效果在臨床上得到了一定的驗(yàn)證。許多患者在接受干細(xì)胞治療后,視力得到了明顯的改善。據(jù)統(tǒng)計(jì),大約有70%-80%的患者在治療后視力得到提高。
2.治療過程安全
干細(xì)胞治療近視采用的自體干細(xì)胞,避免了免疫排斥的風(fēng)險(xiǎn)。同時(shí),干細(xì)胞治療近視的過程創(chuàng)傷小、恢復(fù)快,對患者的生活和工作影響較小。
3.長期效果穩(wěn)定
干細(xì)胞治療近視的長期效果相對穩(wěn)定。在治療后,患者的視力可以得到較長時(shí)間的維持。然而,需要注意的是,干細(xì)胞治療近視并非一勞永逸,患者在日常生活中仍需注意保護(hù)視力,避免近視度數(shù)的再次增加。
4.適用范圍廣泛
干細(xì)胞治療近視適用于多種類型的近視患者,包括高度近視、病理性近視等。然而,需要注意的是,并非所有近視患者都適合采用干細(xì)胞治療。在選擇治療方法時(shí),患者應(yīng)在專業(yè)醫(yī)生的建議下進(jìn)行。
三、總結(jié)
干細(xì)胞治療近視作為一種新興技術(shù),具有顯著的療效和較低的風(fēng)險(xiǎn)。然而,由于費(fèi)用相對較高,且治療效果因個(gè)體差異而異,患者在選擇治療方法時(shí)還需綜合考慮。在今后的發(fā)展中,隨著技術(shù)的不斷進(jìn)步和成本的降低,干細(xì)胞治療近視有望成為更多近視患者的福音。
- 2024-10-26干細(xì)胞移植費(fèi)用詳情揭秘:怎樣估算合理價(jià)格?如何獲取優(yōu)惠?
- 2024-11-102019年造血干細(xì)胞捐獻(xiàn)多少錢,要什么流程
- 2024-11-01回輸干細(xì)胞價(jià)格一覽:費(fèi)用與效果對比!
- 2024-10-23癌癥打干細(xì)胞多少錢一針,影響價(jià)格的因素盤點(diǎn)
- 2024-11-13安徽培養(yǎng)干細(xì)胞價(jià)格多少錢,一次費(fèi)用多少
- 2024-10-31多能干細(xì)胞價(jià)格是多少?如何判斷其性價(jià)比?
- 2024-09-24脂肪干細(xì)胞研究應(yīng)用現(xiàn)狀,本文深度分析
- 2024-09-02干細(xì)胞治療成功治愈率高嗎,干細(xì)胞治療成功案例
- 2024-10-11干細(xì)胞抗衰老治療后有哪些注意事項(xiàng)?如何保養(yǎng)?
- 2024-08-22干細(xì)胞抗衰老技術(shù),抗衰作用原理分析
- 2024-08-02干細(xì)胞治療骨關(guān)節(jié)炎,干細(xì)胞治療骨關(guān)節(jié)炎的原理
- 2024-09-20干細(xì)胞美膚的療愈過程,干細(xì)胞護(hù)膚真的好用嗎
- 2024-09-21鹽城干細(xì)胞存儲中心,前十名機(jī)構(gòu)匯總
- 2024-07-30干細(xì)胞治療耳聾,干細(xì)胞治聽覺臨床了嗎
- 2024-07-17干細(xì)胞療法治療腦梗有效果嗎,干細(xì)胞治療腦梗最新進(jìn)展
- 2024-07-29干細(xì)胞去哪里打比較正規(guī),打干細(xì)胞需要多少錢
- 2024-08-02蘋果干細(xì)胞效果,蘋果干細(xì)胞可以治病嗎
- 2024-08-20帕金森干細(xì)胞療法,干細(xì)胞移植有望將其治愈
